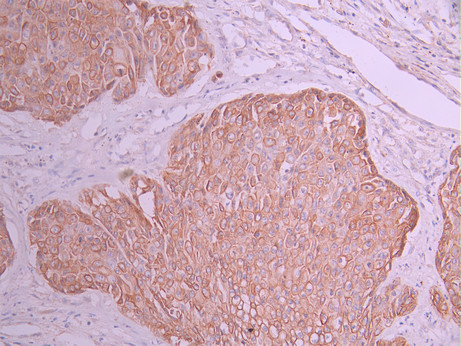

ATG5 Recombinant Monoclonal Antibody
-
中文名稱:ATG5 Recombinant Monoclonal Antibody
-
貨號(hào):CSB-RA050869A0HU
-
規(guī)格:¥1320
-
圖片:
-
Western Blot
Positive WB detected in: HT-29 whole cell lysate(30μg), HepG2 whole cell lysate(30μg), HEK293T whole cell lysate(30μg), SH-SY5Y whole cell lysate(30μg), NIH/3T3 whole cell lysate(30μg)
All lanes: ATG5 antibody at 1:1000
Secondary
Goat polyclonal to rabbit IgG at 1/40000 dilution
Predicted band size: 32 kDa
Observed band size: 55 kDa
Exposure time:2min -
IHC image of CSB-RA050869A0HU diluted at 1:100 and staining in paraffin-embedded human pancreatic cancer performed on a Leica BondTM system. After dewaxing and hydration, antigen retrieval was mediated by high pressure in a citrate buffer (pH 6.0). Section was blocked with 10% normal goat serum 30min at RT. Then primary antibody (1% BSA) was incubated at 4°C overnight. The primary is detected by a Goat anti-rabbit polymer IgG labeled by HRP and visualized using 0.05% DAB.
-
IHC image of CSB-RA050869A0HU diluted at 1:100 and staining in paraffin-embedded human kidney tissue performed on a Leica BondTM system. After dewaxing and hydration, antigen retrieval was mediated by high pressure in a citrate buffer (pH 6.0). Section was blocked with 10% normal goat serum 30min at RT. Then primary antibody (1% BSA) was incubated at 4°C overnight. The primary is detected by a Goat anti-rabbit polymer IgG labeled by HRP and visualized using 0.05% DAB.
-
Overlay Peak curve showing 786-O cells stained with CSB-RA050869A0HU (red line) at 1:100. The cells were fixed in 4% formaldehyde and permeated by 0.2% TritonX-100 for 10min. Then 10% normal goat serum to block non-specific protein-protein interactions followed by the antibody (1ug/1*106cells) for 45min at 4℃. The secondary antibody used was FITC-conjugated goat anti-rabbit IgG (H+L) at 1/200 dilution for 35min at 4℃.Control antibody (green line) was Rabbit IgG (1ug/1*106cells) used under the same conditions. Acquisition of >10,000 events was performed.
-
-
其他:
產(chǎn)品詳情
-
Uniprot No.:
-
基因名:
-
別名:Autophagy protein 5 (APG5-like) (Apoptosis-specific protein), ATG5, APG5L ASP
-
反應(yīng)種屬:Human, Mouse
-
免疫原:A synthesized peptide from human ATG5 protein
-
免疫原種屬:Homo sapiens (Human)
-
標(biāo)記方式:Non-conjugated
-
克隆類型:Monoclonal
-
抗體亞型:Rabbit IgG
-
純化方式:Affinity-chromatography
-
克隆號(hào):5E10
-
濃度:It differs from different batches. Please contact us to confirm it.
-
保存緩沖液:Preservative: 0.03% Proclin 300
Constituents: 50% Glycerol, 0.01M PBS, PH 7.4 -
產(chǎn)品提供形式:Liquid
-
應(yīng)用范圍:ELISA, WB, IHC, FC
-
推薦稀釋比:
Application Recommended Dilution WB 1:500-1:2000 IHC 1:50-1:200 FC 1:50-1:200 -
Protocols:
-
儲(chǔ)存條件:Upon receipt, store at -20°C or -80°C. Avoid repeated freeze.
-
貨期:Basically, we can dispatch the products out in 1-3 working days after receiving your orders. Delivery time maybe differs from different purchasing way or location, please kindly consult your local distributors for specific delivery time.
-
用途:For Research Use Only. Not for use in diagnostic or therapeutic procedures.
相關(guān)產(chǎn)品
靶點(diǎn)詳情
-
功能:Involved in autophagic vesicle formation. Conjugation with ATG12, through a ubiquitin-like conjugating system involving ATG7 as an E1-like activating enzyme and ATG10 as an E2-like conjugating enzyme, is essential for its function. The ATG12-ATG5 conjugate acts as an E3-like enzyme which is required for lipidation of ATG8 family proteins and their association to the vesicle membranes. Involved in mitochondrial quality control after oxidative damage, and in subsequent cellular longevity. Plays a critical role in multiple aspects of lymphocyte development and is essential for both B and T lymphocyte survival and proliferation. Required for optimal processing and presentation of antigens for MHC II. Involved in the maintenance of axon morphology and membrane structures, as well as in normal adipocyte differentiation. Promotes primary ciliogenesis through removal of OFD1 from centriolar satellites and degradation of IFT20 via the autophagic pathway.; May play an important role in the apoptotic process, possibly within the modified cytoskeleton. Its expression is a relatively late event in the apoptotic process, occurring downstream of caspase activity. Plays a crucial role in IFN-gamma-induced autophagic cell death by interacting with FADD.; (Microbial infection) May act as a proviral factor. In association with ATG12, negatively regulates the innate antiviral immune response by impairing the type I IFN production pathway upon vesicular stomatitis virus (VSV) infection. Required for the translation of incoming hepatitis C virus (HCV) RNA and, thereby, for initiation of HCV replication, but not required once infection is established.
-
基因功能參考文獻(xiàn):
- variants have role in susceptibility to systemic lupus erythematousus PMID: 29759048
- Consistently, forced expression of p53 significantly stimulated ACER2 transcription. Notably, p53-mediated autophagy and apoptosis were markedly enhanced by ACER2. Depletion of the essential autophagy gene ATG5 revealed that ACER2-induced autophagy facilitates its effect on apoptosis. PMID: 28294157
- DICER1-AS1 regulates the proliferation, invasion and autophagy of osteosarcoma via miR-30b/ATG5 axis. PMID: 29772430
- ATG5 levels were significantly different between chronic total coronary occlusion, acute total coronary occlusion (myocardial infarction) and control groups. PMID: 29455545
- Data show that miR-181a binds to the 3' untranslated regions (3'-UTR) of autophagy-related protein 5 (Atg5). PMID: 28930552
- Our results suggest that these three genes that are critical components of the autophagy pathway (ATG16L, ATG2B, ATG5) are not significant risk factors among Spanish patients with either pseudoexfoliation syndrome or pseudoexfoliation glaucoma. PMID: 27960588
- The results support the association of SNPs in ATG5 and CRP genes with response to adalimumab therapy in Crohn's disease. PMID: 27096233
- Atg5-mediated autophagy in proximal epithelial cells is a critical host-defense mechanism that prevents renal fibrosis by blocking G2/M arrest PMID: 27304991
- knockdown of autophagy genes ATG5 or ATG7 resulted in reduced hematopoietic stem/progenitor cell frequencies in vitro as well as in vivo. PMID: 26930546
- Data suggest that Atg5 expression level in dopaminergic (DA) neurons is decreased and autophagy flux is blocked in zebrafish MPTP model of Parkinson's disease (PD); gene therapy in embryo/larva resulting in human ATG5 overexpression reverses PD pathological features, rescues DA neurons, and restores autophagy flux in DA neurons; thus, ATG5 plays role in neuroprotection. PMID: 28928221
- Kaposi sarcoma-associated herpesvirus reduces CAST (calpastatin) and consequently decreases ATG5 expression in both THP-1 monocytoid cells and primary monocytes. PMID: 27715410
- These results support ATG5 as a therapeutically relevant dose-dependent rheostat of melanoma progression. PMID: 27464255
- Confirm the association of rs548234/ATG5, rs2736340/BLK and rs10516487/BANK1 with systemic lupus erythematosus in Chinese Han and reinforced our hypothesis of their epistasis effect in regulating B-cell signaling in SLE. PMID: 26420661
- Neither eosinophils nor neutrophils require ATG5-dependent autophagy for extracellular DNA trap formation. PMID: 28703297
- ATG5 rs510432 gene polymorphism might be related to the occurrence of coal workers' pneumoconiosis in a Chinese population. PMID: 28844669
- The expression levels of ATG5 and LC3 were associated with classification, histological grade, TNM stage and survival rate in renal carcinoma. PMID: 28274318
- the scaffold protein RACK1 is a new ATG5-interacting protein and an important and novel component of the autophagy pathways. PMID: 27325703
- UA exerted antiatherosclerosis effects in quails and protected HUVECs from ox-LDL induced cytotoxicity, and the mechanism is associated with increased SIRT1 expression, decreased Atg5 acetylation on lysine residue, and increased autophagy. PMID: 27514536
- Genetic polymorphisms of ATG5 and ATG7 could contribute to neutrophilic airway inflammation in the pathogenesis of adult asthma. PMID: 26701229
- The authors identified a homozygous missense mutation, changing a conserved amino acid, in ATG5 in two siblings with congenital ataxia, mental retardation, and developmental delay. PMID: 26812546
- study established a relationship between trans-eSNPs of ATG5 and lupus nephritis in a northern Han population from China PMID: 26509176
- in the presence of 3-MA and Atg5 siRNA, autophagy was inhibited, LC3-II expression decreased and cell apoptosis increased PMID: 26240015
- This study demonstrated an association of ATG5 rs573775 with BD and ATG10 rs4703863 with VKH syndrome in a Chinese Han population. PMID: 26747760
- provide an insight into a model for swapping ATG5 partners for autophagosome maturation PMID: 25787994
- the crystal structures of human ATG5 in complex with an N-terminal domain of ATG16L1 as well as an internal AIR domain of TECPR1, are reported. PMID: 25484072
- Taken together, the results demonstrate that ATG5 cleavage provokes apoptosis and represents a molecular link between autophagy and apoptosis PMID: 25481044
- Increased frequencies of rare variants of ATG5 were identified in patients with LN and Systemic Lupus Erythematosus compared with healthy controls, highlighting a likely important role of rare ATG5 variants in Chinese SLE patients. PMID: 26039132
- Increased expression of ATG5 was significantly correlated with poor overall survival and chemoresistance in gastric cancer. PMID: 25329677
- Results indicated that ATG5 variants are associated with NMO but not MS patients, which may provide a clue for further clarifying the autoimmune mechanisms of autophagy-related pathogenesis in NMO. PMID: 24953774
- ATG5-expressing cells showed elevated p53 levels and increased p53 activation. PMID: 25032862
- Genetic variation in ATG5 is associated with increased susceptibility for thyroid carcinoma. PMID: 24739953
- Globular adiponectin restores ethanol-suppressed autophagy-related protein 5 (Atg5) expression in HepG2 cells. PMID: 24582693
- both autophagy-related 5 and microtubule-associated protein 1 light chain 3B levels are decreased in patients with melanomas as compared with those with benign nevi PMID: 24300435
- Atg5 rs573775 T* allele seems to influence SLE susceptibility, cytokine production and disease features depending on other factors such as functional IL-10 genotype PMID: 24205307
- down-regulation of ATG5 contributes to tumorigenesis in early-stage cutaneous melanoma. PMID: 24027027
- In dopaminergic cells, Atg5-dependent autophagy acts as a protective mechanism during apoptotic cell death induced by paraquat and MPP but not during rotenone or 6-OHDA toxicity. PMID: 23997112
- sublethal concentrations of DNA-damaging drugs, such as etoposide and cisplatin, induce the expression of autophagy-related protein 5, which is both necessary and sufficient for the subsequent induction of mitotic catastrophe. PMID: 23945651
- It was concluded taht granulysin induces apoptosis on hematological tumor cells and on cells from B-cell lymphocytic leukemia patients, opening the door to research on its use as a new anti-tumoral treatment. PMID: 24269628
- These results suggested that calpain, Bak and Atg5 were molecular links between autophagy and apoptosis and revealed novel aspects of the crosstalk between these two processes. PMID: 23242420
- PDCD4 negatively regulates autophagy by targeting ATG5. PMID: 23486359
- MIR181A is a novel and important regulator of autophagy and ATG5 is a rate-limiting miRNA target in this effect PMID: 23322078
- MAPK14-mediated phosphorylation of ATG5 has a role in inhibiting autophagocytosis PMID: 23235332
- Autophagy is differentially induced in prostate cancer LNCaP, DU145 and PC-3 cells via distinct splicing profiles of ATG5. PMID: 23075929
- the variant identified in PD patient may change ATG5 protein levels and alter autophagy activities, contributing to Parkinson's disease onset as a risk factor. PMID: 23384565
- ATG-5 down-regulation is associated with hepatocellular carcinoma infected with hepatitis C virus. PMID: 23317196
- Immunohistochemical analysis of colorectal cancer tissues indicated that increased ATG5 expression is associated with lymphovascular invasion. PMID: 22993366
- Genetic variants in ATG5, including a functional promotor variant, are associated with childhood asthma. PMID: 22536318
- Results showed no involvement of rs548234 at PRDM1-ATG5 region in the susceptibility or clinical relevance of RA in Chinese Han population. PMID: 22040493
- doxorubicin switches protective autophagy in SPP1-depleted cells to apoptosis by calpain-mediated Atg5 cleavage. PMID: 22052905
- overexpression of ATG5 gene may be related to autophagy and might play a role in prostate tumorigenesis. PMID: 21995634
顯示更多
收起更多
-
相關(guān)疾病:Spinocerebellar ataxia, autosomal recessive, 25 (SCAR25)
-
亞細(xì)胞定位:Cytoplasm. Preautophagosomal structure membrane; Peripheral membrane protein.
-
蛋白家族:ATG5 family
-
組織特異性:Ubiquitous. The mRNA is present at similar levels in viable and apoptotic cells, whereas the protein is dramatically highly expressed in apoptotic cells.
-
數(shù)據(jù)庫(kù)鏈接:
Most popular with customers
-
-
YWHAB Recombinant Monoclonal Antibody
Applications: ELISA, WB, IHC, IF, FC
Species Reactivity: Human, Mouse, Rat
-
Phospho-YAP1 (S127) Recombinant Monoclonal Antibody
Applications: ELISA, WB, IHC
Species Reactivity: Human
-
-
-
-
-